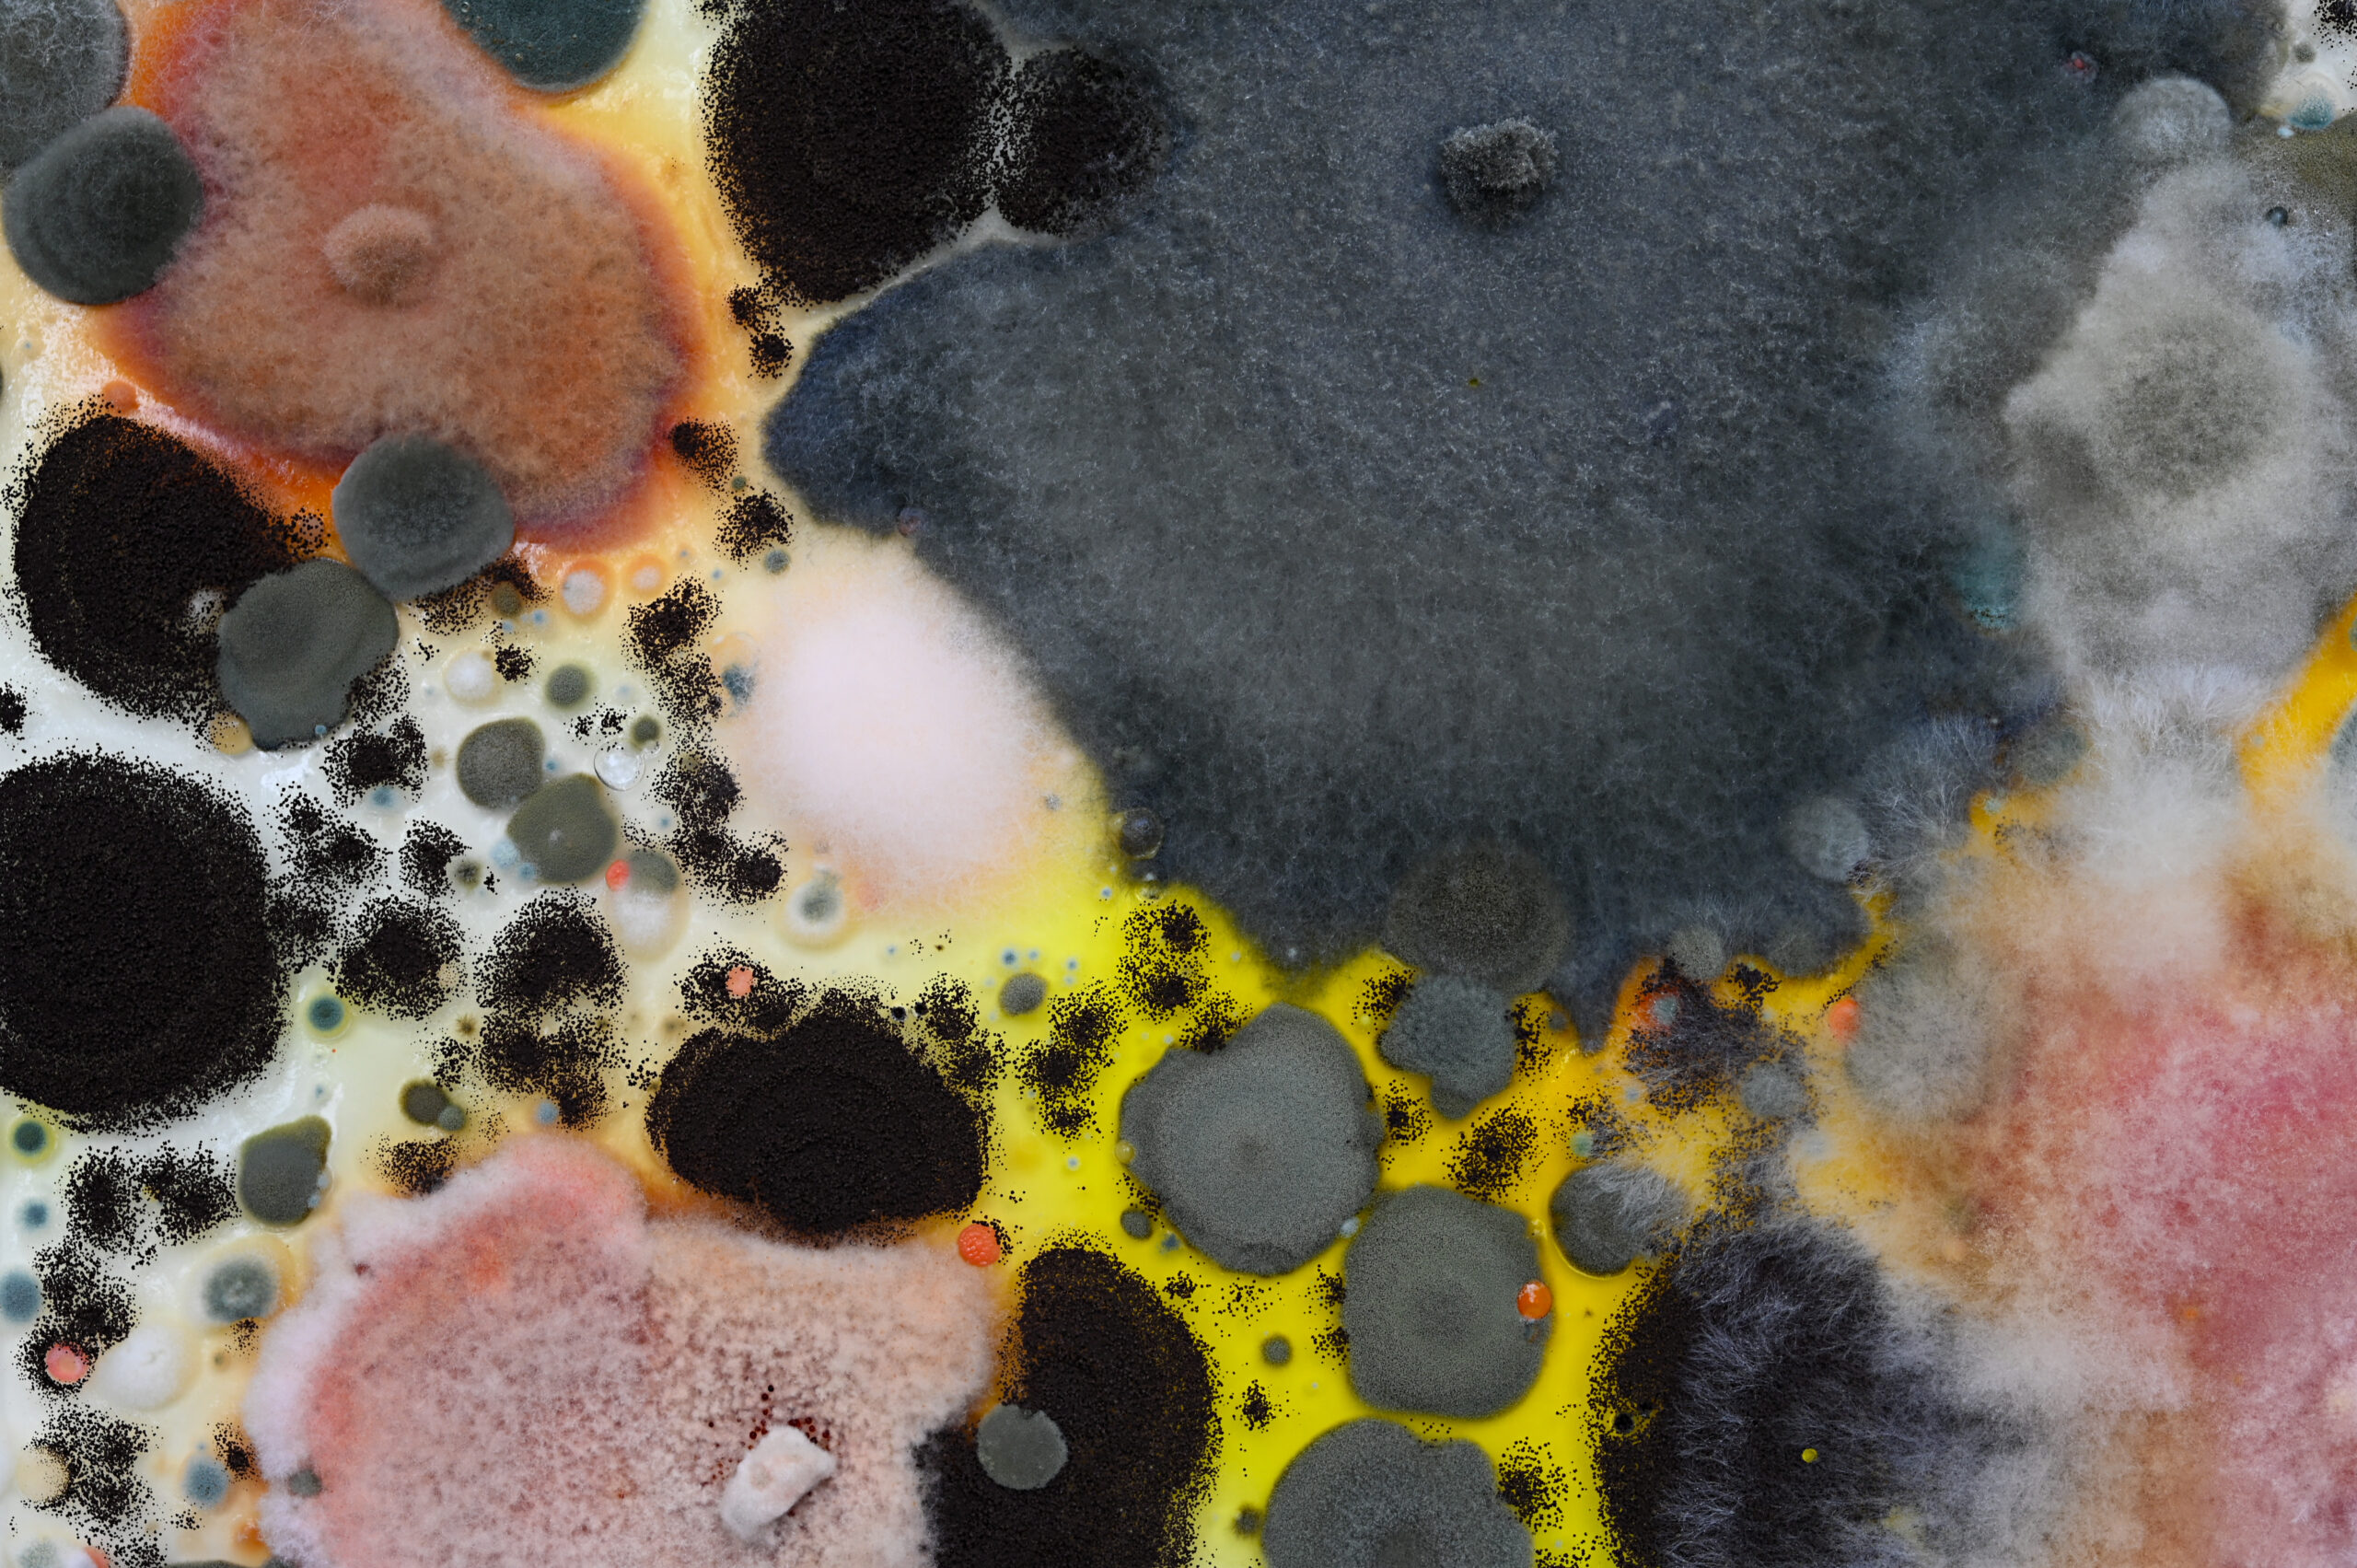

Breakdown
The Promise of Decay
January 25, 2025 - April 26, 2026

Tolypocladium paradoxum From the series Mushrooms & Friends Phyllis Ma Photograph, 2019-Present
Breakdown: The Promise of Decay
January 25, 2025 – April 26, 2026
Introduction
Breakdown: The Promise of Decay examines the vibrancy of decay. This interdisciplinary exhibition explores notions of time, waste, and the in-between. Breakdown shines a light on the dark corners of the life cycle recognizing the oft-overlooked workhorses of the ecosystem. From mycelium to microplastics, this exhibition focuses on what breaks down and what does not.
Plastic pollution is one of the most serious environmental challenges in the 21st century. Microplastics, tiny pieces of non-biodegradable plastic, thwart the pressures of time and decomposition. They are ubiquitous, like fungi: found outdoors in soil and on plants, indoors on surfaces and in the air, on our skin and inside the body. In the end, it comes from our stuff – which is everywhere.
Featuring contemporary artwork, objects from the museum’s collection, and scientific innovations in the curious world of decomposition, Breakdown asks the public to value a world they cannot see in order to protect the one we can.
Curated by Rylee Eterginoso and Colleen Evans

The Storm Jade Doskow Archival Giclée Print, 2022
Featured Artists:
Selin Balci
Jade Doskow
Tamara Kostianovsky
Phyllis Ma
Antonia A. Perez
Lisa Ann Schonberg
With contributions by Dr. Martin Melosi, Louis Vassar Semanchik and Michael Falco.
Freshkills, Photographs by Jade Doskow, Original music composition by Heather Campanelli Video, 2024
This piece will be exhibited in the Auditorium of the Staten Island Museum for the duration of Breakdown: The Promise of Decay.